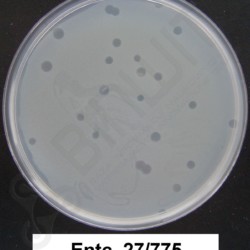
Bakteriofag

Terapia fagowa jest metodą leczenia zakażeń bakteryjnych wykorzystującą unikalne właściwości bakteriofagów – wirusów bakteryjnych atakujących wyłącznie komórki bakteryjne.
Bakteriofagi (zwane też fagami) mogą skutecznie niszczyć rożne bakterie, w tym te, które nabyły odporność na antybiotyki. Metoda leczenia zakażeń bakteryjnych przy użyciu fagów znana jest na świecie od początku XX wieku.


Sformułowana w latach 2005-2008 hipoteza o ochronnym działaniu fagów endogennych (występujących w organizmach, m.in. w przewodzie pokarmowym) wraz z potencjałem immunomodulacyjnym fagów wskazała implikacyjne możliwości zastosowania fagoterapii w leczeniu chorób o podłożu autoimmunologicznym, alergii, choroby przeszczep-przeciw-gospodarzowi, zwalczania odrzucania alloprzeszczepu oraz zakażeń nie-bakteryjnych (wirusowe i grzybicze).
Właściwości immunomodulacyjne potwierdzone zostały eksperymentalnie.
Instytut Immunologii i Terapii Doświadczalnej im. Ludwika Hirszfelda PAN we Wrocławiu prowadzi badania nad właściwościami biologicznymi i zastosowaniem bakteriofagów w terapii od kilkudziesięciu lat. Dysponuje metodami izolacji fagów oraz przygotowywania preparatów fagowych do terapii.
Od lat 70. XX wieku są one stosowane przez różne polskie szpitale w koordynowanej przez Instytut terapii fagowej zakażeń bakteryjnych.